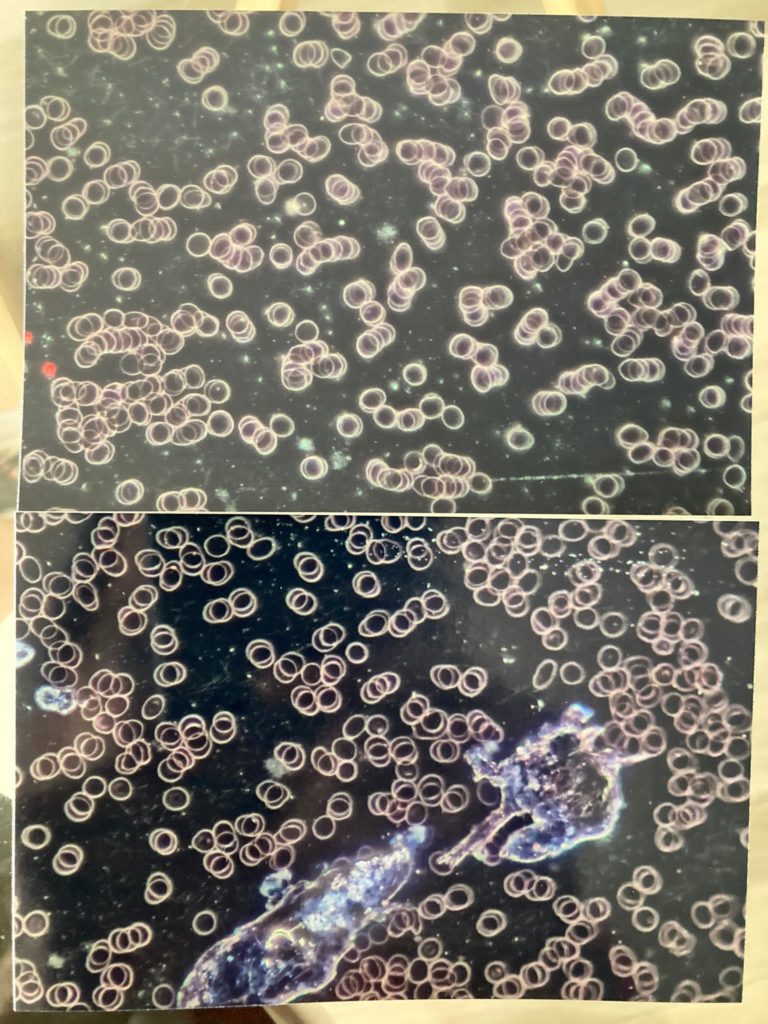

Cos’è la MiCo
La microscopia in campo oscuro (MiCo) è una metodica che consente di valutare l’ambiente interno dell’organismo a partire dall’analisi di una goccia di sangue vivo, fornendo a schermo immagini visive, reali ed immediate, del nostro sangue..
Fornisce quindi utili informazioni in merito al reale stato di salute dell’organismo, alle qualità e caratteristiche del plasma, delle cellule e delle altre componenti ematiche, oltre alla presenza di eventuali agenti patogeni.
E’ un esame che completa ed amplia le informazioni delle classiche analisi sierologiche ed è particolarmente indicato nella valutazione delle malattie croniche, nelle infezioni batteriche o fungine sistemiche così come nella loro suscettibilità.
In aggiunta, la microscopia in campo oscuro può evidenziare eventuali processi alla base delle malattie e consente di ottenere informazioni relative alla tossicità cronica cui è esposto l’organismo, di origine sia endogena che ambientale.
Le evidenze che emergono grazie alla microscopia in campo oscuro, in affiancamento alle tradizionali analisi del sangue, possono guidare gli specialisti nella personalizzazione delle terapie biologiche.
Utilizzo della MiCo in Nutripuntura®
Già nel 1997, il medico reumatologo Dr. Michele Licciardello, affiancato dal Dr. Patrick Véret medico e fondatore della Nutripuntura®, ha condotto numerosi studi e ricerche su pazienti affetti da malattie reumatiche (artrite reumatoide, lupus, etc.).
Grazie all’analisi osservazionale del sangue vivo in campo oscuro, ha constatato delle modificazioni degli elementi del sangue, in particolare a livello dei globuli rossi, che nel campione apparivano inizialmente impilati e con scarsa cinesi.
A seguito dell’assunzione di specifiche sequenze di complessi poliminerali (NUTRI), attraverso un secondo prelievo, i globuli rossi apparivano invece con buona cinesi e distanziati.
In questo ambito appare quindi evidente l’effetto delle sequenze di NUTRI che vengono personalizzate in funzione del terreno specifico della persona, della patologia, dei sintomi e della storia clinica.


Le evidenze nel trattamento delle reazioni avverse da vaccino Covid
La microscopia in campo oscuro è stata recentemente utilizzata anche per ricercare indicazioni utili a persone che hanno subito reazioni avverse a seguito delle vaccinazioni per il Covid.
In questo ambito, alcuni specialisti hanno osservato una dinamica del sangue simile a quella dei pazienti osservati dal Dr. Licciardello, ovvero con globuli rossi impilati, acinetici, con l’aggiunta di alcune macromolecole ed elementi non biologici.
Grazie a queste osservazioni, sono stati messi a punto alcuni protocolli di disintossicazione, per sostenere l’organismo sia nel recupero dei sintomi funzionali, sia nel ritrovare una dinamica sanguigna vitale, con globuli rossi ben distanziati.
Le esperienze finora raccolte (le ricerche del Dr. Véret in questo ambito sono ancora in corso ed i risultati verranno pubblicati quando ultimate) mostrano che i complessi NUTRI, così opportunamente combinati ed assunti per circa un mese, sono efficaci nel sostenere la disintossicazione dell’organismo, con risultati che sono osservabili anche attraverso la metodica MiCo.
(fonte: https://nutripuntura.it)
Esperienze dirette e testimonianze
I più frequenti effetti avversi riferibili alla fase post-vaccino riportati dalle persone sono stati:
– stanchezza cronica
– scarsa lucidità mentale
– difficoltà motorie e respiratorie
– miastenie, aritmie, miocarditi, pericarditi
– alterazione della pressione sanguigna
– extrasistole
– alterazioni delle dinamiche circolatorie (ciclo m., disturbi del fegato e circolatori)
– calcoli biliari
– insorgenza o acutizzazione di problematiche preesistenti (fibromialgia, artrite reumatoide, mialgia)
– disturbi sensoriali (percettivi, nevralgici, acufeni, alterazione di gusto ed olfatto, diplopia)
– dolori muscolari ed articolari, dolori diffusi
– bruciori alla gola (dal torace), dietro le orecchie, dietro la testa
– neuropatia delle piccole fibre
– parestesie (es. gamba che brucia)
– squilibri ormonali (tiroide, timo)
– arrossamenti cutanei
– dolore invalidante al braccio in sede di inoculazione anche dopo molti mesi
Per la maggior parte di questi disturbi riferiti non è stata fornita nessuna diagnosi specifica.
Tutti i casi che hanno deciso di effettuare lo specifico protocollo detox per tali informazioni, hanno beneficiato sin dai primi giorni di miglioramenti, a volte sorprendenti, derivanti dal ripristino di una corretta dinamica del sangue.
Chi avesse la possibilità di effettuare un esame del sangue MiCo prima e dopo il protocollo detox potrebbe riscontrare differenze come queste che una paziente ci ha messo con entusiasmo a disposizione.

Continuiamo a raccogliere testimonianze di pazienti che effettuano questo protocollo, invitandoli a condividere, nell’interesse comune e della ricerca, tutti i cambiamenti e gli esiti riscontrati con il protocollo stesso, per confermare l’ampiezza delle casistiche e poter aiutare un numero maggiore di persone a riprendere in mano le redini della propria vita e ritrovare il proprio equilibrio e la Salute.
Ci sono state anche testimonianze di ricomparsa del ciclo mestruale in pazienti giovani dopo molti mesi di amenorrea secondaria, ripristino delle normali funzionalità ghiandolari alterate, riduzione dei dolori muscolari, riequilibrio delle funzioni cutanee e neurologiche.
Essendo tutti diversi ed unici, ognuno di noi ha una propria capacità di reazione in questi contesti e, oltre a tutte le possibili sovrapposizioni, risulta determinante il fattore temporale.
Maggiore è il tempo che viene trascorso in condizioni di squilibrio e maggiori saranno gli effetti tossici ed i danni ai sistemi che, se protratti a lungo, possono diventare irreversibili.
Uno stile di vita corretto ed una prevenzione/azione immediata in questo caso possono fare la differenza della qualità futura della nostra Salute.
Vi invitiamo a valutare (ed a provare) gli specifici protocolli detox di Nutripuntura® per queste problematiche.
Endocoaching® mette a disposizione un nutripuntore certificato per fornire ogni informazione al riguardo attraverso i canali presenti su questo sito, in modalità online o in presenza.
Ricordiamo nuovamente che la Nutripuntura® non appartiene né vuole sostituirsi alla medicina tradizionale, alla quale può comunque affiancarsi, in modo naturale e senza alcuna interazione o controindicazione, agendo a livello informazionale cellulare, volto al ripristino della migliore proiezione identitaria dell’individuo.
.

Cliccando qui potrete visualizzare l’articolo che descrive nel dettaglio la modalità di effettuazione del test di impatto.
